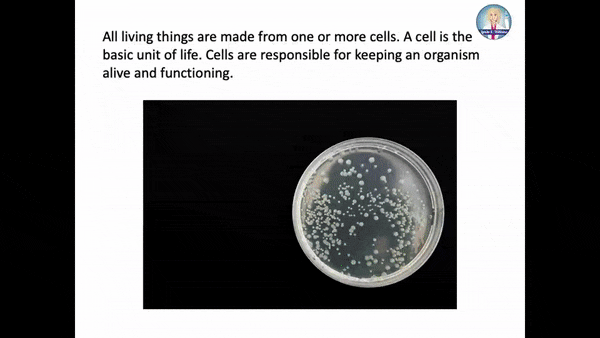

Need a little help teaching your middle school science class about cell structure and function?
This unit has great cell activities for middle school. Students will learn about cell parts and functions. Making a model of animal and plant cells is a great start to discussing structure and function within cells.
Students will learn about animal cell function and plant cell function. Students will label the plant and animal cells. Students will enjoy making a plant cell model and an animal cell model and the cell organelle worksheets. Students love to put these models into their interactive notebooks. Perfect for Utah SEEd 7th grade plant cell parts and functions as well as an NGSS MS Life Science on Cells.
This complete unit will save you lots of time and keep your students engaged!

Your class will LOVE these cell activities!
Students will plan and carry out investigations to provide evidence that living things are made of cells, they will learn that each organelle of the cell contributes to the function of the cell, and your class will learn about animal cells and plant cells and they will recognize that there are differences and similarities between them.
Interactive notebook flaps can be used to record the function of each part of the cell. Students will learn the difference between plant and animal cells. Students will compare plant and animal cells. This unit is perfect for Middle School NGSS and 7th grade Utah SEEd Study of cells and cell parts and function and making a model of a cell. Human Systems is also a middle school standard. Students will also love learning about the human brain and sensory receptors.
If you use the suggested schedule I’ve included, this unit will cover seventeen days of lessons!
The unit begins with a PowerPoint slideshow to give basic information on cells:
An informational text passage on cells is included with response pages:

Interactive notebook flaps and folds are also included:

Students will complete an activity giving them the chance to label the parts of a cell:

Students can also participate in QR code research and complete two structured labs: one lab on human cheek cells and one lab on onion cells.
There are smaller pieces called organelles that make up the cell. A mitochondrion is an example of an organelle. Cells can also connect to form larger structures. They might group together to form the tissues of the stomach and eventually the entire digestive system. However, in the same way, that atoms are the basic unit when you study matter, cells are the basic unit for biology and organisms.
Students will love this cell structure and function worksheets. In larger organisms, the main purpose of a cell is to organize. Cells hold a variety of pieces and each cell type has a different purpose. By dividing responsibilities among different groups of cells, it is easier for an organism to survive and grow.

A third lab is included that has students planning and carrying out their own investigation on cells.
Recording sheets are included for each lab and the unit ends with a multiple-choice quiz. Answer keys are included for everything!
This is a standards aligned unit created to teach NGSS MS-LS1-1 and NGSS MS-LS1-2 as well as Utah SEEd 7.3.1 and 7.3.2.
Conduct an investigation to provide evidence that living things are made of cells; either one cell or many different numbers and types of cells. [Clarification Statement: Emphasis is on developing evidence that living things are made of cells, distinguishing between living and non-living things, and understanding that living things may be made of one cell or many and varied cells.]
NGSS MS-LS1-1
Develop and use a model to describe the function of a cell as a whole and ways the parts of cells contribute to the function. [Clarification Statement: Emphasis is on the cell functioning as a whole system and the primary role of identified parts of the cell, specifically the nucleus, chloroplasts, mitochondria, cell membrane, and cell wall.] [Assessment Boundary: Assessment of organelle structure/function relationships is limited to the cell wall and cell membrane. Assessment of the function of the other organelles is limited to their relationship to the whole cell. Assessment does not include the biochemical function of cells or cell parts.]
NGSS MS-LS1-2
Other teachers LOVE this unit!
Check out just two of the dozens of perfect ratings:
Wow! My students loved the interactive notebook folds. It was perfectly aligned to the standards. I think the labs were clearly explained and I liked that it included a slide show and informational text passages! Really a well thought out resource.
Elizabeth B.
Thank you for the 3 dimensional lessons that align so well with NGSS. This unit helped me tie the DCI’s to the practices and Crosscutting concepts. Thank you for your hard work!
Shelley K.
This unit is available for download in two places:
Both downloads are identical in every way – if you download directly from this site, you’re giving me the maximum amount of support!
Either way, your satisfaction is 100% guaranteed.
This site uses 100% secure checkout with PayPal, and after checkout, your download is instantly available.
Thank you, and I hope you enjoy using this unit in your classroom!
Would you like a free resource on Carrying Capacity in Ecosystems?
FREE Carrying Capacity Game


